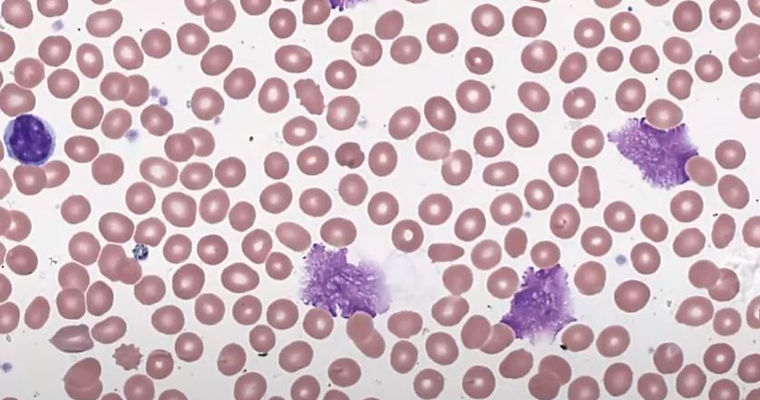
CLL2.JPG
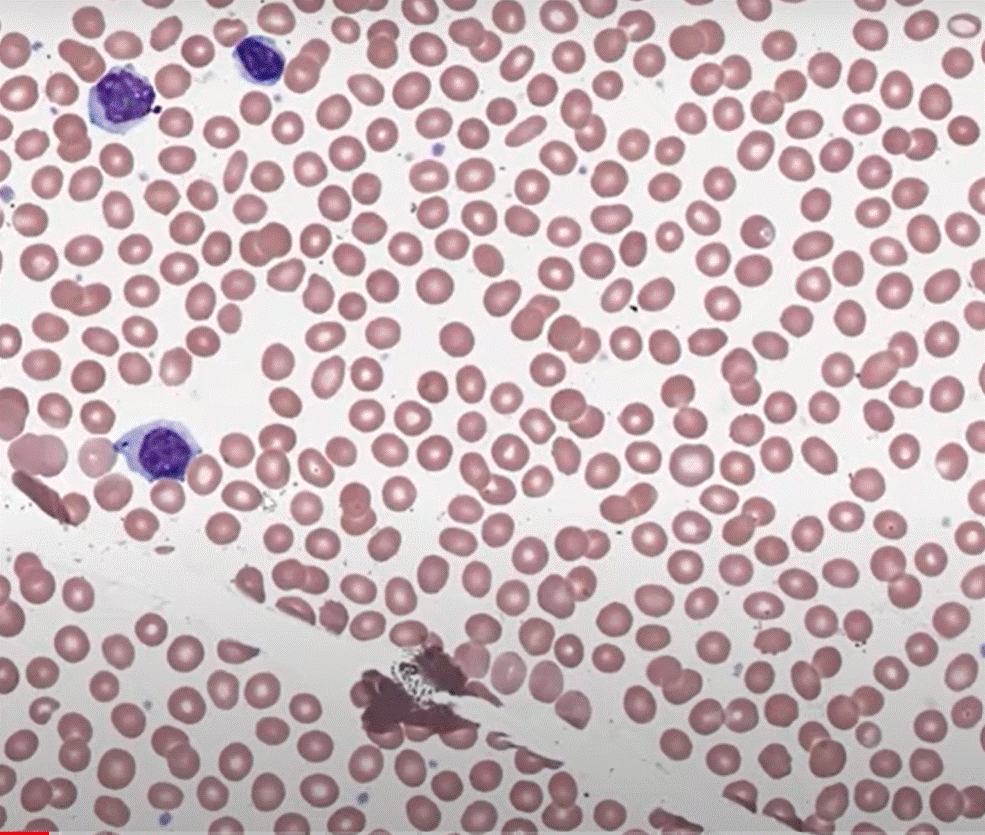
cll3.gif
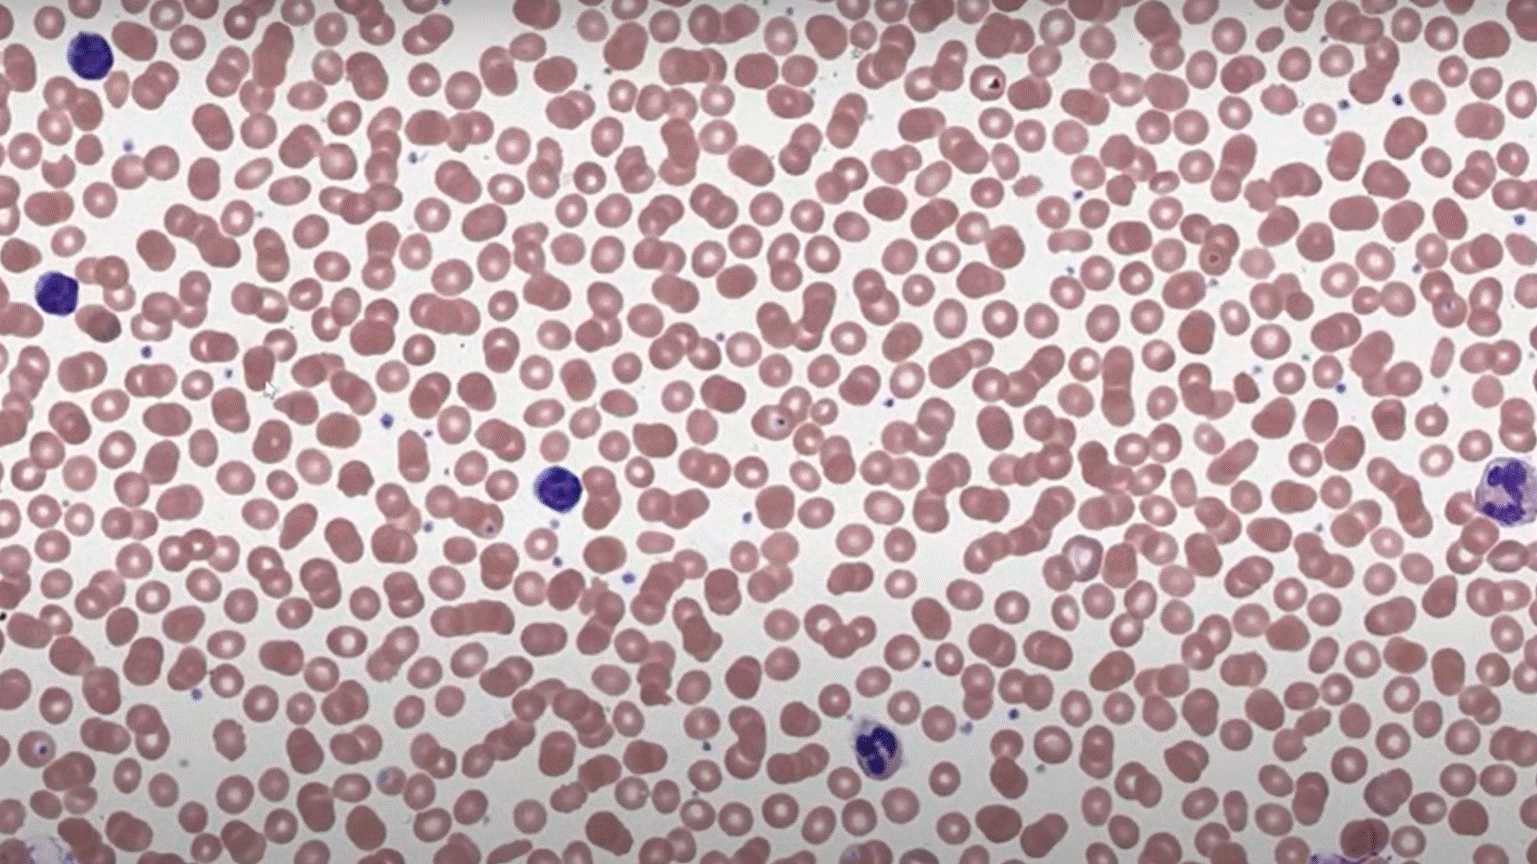
CLL1.gif

top of page
Chronic Lymphocytic Leukemia
This patient presented with lymphocytosis. Peripheral smear examination presents mature yet functionally incompetent lymphocytes and smudge cells.



bottom of page
This patient presented with lymphocytosis. Peripheral smear examination presents mature yet functionally incompetent lymphocytes and smudge cells.